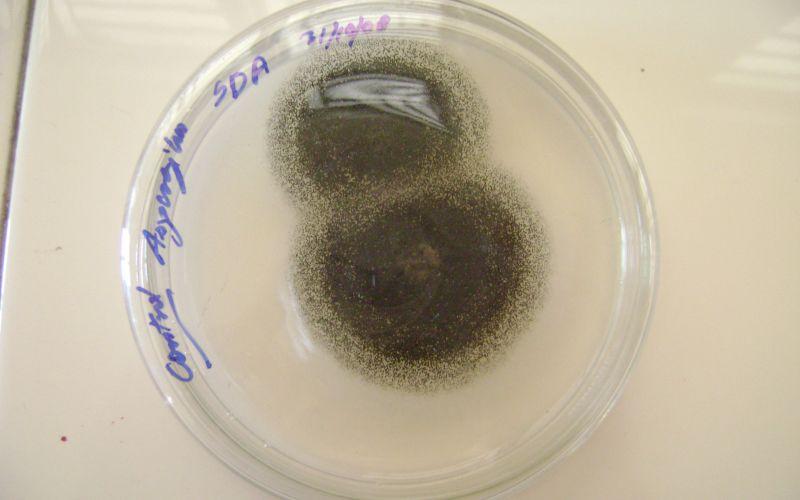

Los hongos mantienen el aspecto típico de un cultivo y, de esta forma, se identifican fácilmente de acuerdo con los caracteres macroscópicos estándar. Este medio difiere del agar dextrosa Sabouraud (CM0041) solo en el carbohidrato incorporado. El agar maltosa Sabouraud puede usarse con o sin antibióticos, donde se prefiera un medio de maltosa.. PREPARACIÓN. sabouraud-dextrose-agar. Disolver 65 g de medio en 1 litro de agua destilada. Calentar agitando hasta ebullición para su disolución. Repartir en tubos o frascos. Autoclavar a 121 ºC durante 15 minutos, o mejor a 116 ºC durante 10 minutos. No sobrecalentar, para evitar la caramelización de la glucosa (color ambar en vez de crema).

Agar Dextrosa Sabouraud con Cloranfenicol SciSols

AGAR DEXTROSA SABOURAUD l AGAR DEXTROSA SABOURAUD MEDIO DE CULTIVO PARA HONGOS l AGAR DEXTROSA

AGAR SABOURAUD DEXTROSA BIOBACTER

Sabouraud Dextrose Agar, pH 5.6; 500g Medix ®, your online laboratory supply shop

AGAR DEXTROSA SABOURAUD. 500G. DIFCO Medlab

Thermo Scientific™ SabouraudDextroseAgar Produkte Fisher Scientific

Placa Ágar Sabouraud Dextrose 4 90mm Plastlabor

Agar Dextrosa Sabouraud con Cloranfenicol y Gentamicina Formato 500 g

Agar Sabouraud Dextrosa SciSols

SABOURAUD DEXTROSE AGAR Agarindo Biological Company

Sabouraud Dextrose Agar (SDA) Composition, Principle, Uses, Preparation ,culture and Colony

Sabouraud Dextrose Agar (SDA) Standard Media

AGAR SABOURAUD DEXTROSA MDM CAJA 90MM X 15MM MDM Científica

211584 BD BBL™ Agar Dextrosa Sabouraud, 500 g PROQUISUR Material de Laboratorio en Mexico
Agar Sabouraud qué es, fundamento, preparación y usos

Top view of a Sabouraud dextrose agar plate culture growing the dermatophytic fungus Microsporum

Agar Dextrosa Sabouraud EP/USP/ISO Formato 500 g

Sabouraud dextrose agar fotografías e imágenes de alta resolución Alamy

Agar dextrosa sabouraud paquete con 10 tubos MCD LAB Grupo JAFS

Public Domain Picture This Sabouraud's dextrose agar plate culture is growing the fungus
La dextrosa es el carbohidrato fermentable que proporciona carbono y energía. La mezcla de peptona proporciona nitrógeno, vitaminas, minerales y aminoácidos esenciales para el crecimiento. El agar bacteriológico es el agente solidificante. La alta concentración de dextrosa y el pH ácido hacen que este medio sea selectivo para los hongos.. La adición de antibióticos de amplio espectro inhibe una amplia gama de bacterias Gram positivas y Gram negativas. El medio de cultivo se siembra de acuerdo a las indicaciones con la muestra de ensayo. Los hongos desarrollados se examinan micro y macroscópicamente. FORMULA EN GRAMOS POR LITRO DE AGUA DESTILADA Agar 15.0 Dextrosa 40.0